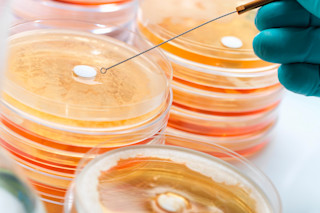

1928年,亚历山大·弗莱明发现了青霉素,但这种革命性的抗生素直到1945年才普及,此前两位牛津科学家开发了必要的规模化生产方法。
在发现到分发之间的17年里,弗莱明继续用少量青霉素对包括葡萄球菌在内的几种细菌病原体进行实验。在此过程中,他发现了近一个世纪以来困扰医学界的一种现象的早期迹象:细菌对青霉素产生耐药性,甚至免疫的可能性。
他在1940年发现了这种耐药性潜力,就在青霉素广泛使用前五年,并因此项发现获得了诺贝尔医学奖。
“我想发出一个警告……在实验室里,通过将微生物暴露在不足以杀死它们的浓度下,很容易使它们对青霉素产生耐药性,而且在人体内偶尔也会发生同样的情况。”
— 亚历山大·弗莱明,1945年
自从弗莱明首次预见到麻烦以来,研究人员在发布抗生素后一直遇到同样的问题。例如,当四环素于1950年上市时,它对被诊断患有多种细菌感染的人来说是一个福音,包括痢疾杆菌,一种可导致每天腹泻20多次的肠道细菌。但到1959年,痢疾杆菌菌株已经对四环素产生了耐药性。
这些治疗窗口很快开始更快地关闭。自从1960年引入甲氧西林以来,葡萄球菌菌株仅用了两年时间就对其产生了耐药性。1996年,当左氧氟沙星开始处方时,当年就出现了一种肺炎链球菌菌株对其产生耐药性。
最新的统计数据也令人担忧。美国疾病控制与预防中心保守估计,在美国,每年有超过200万人因抗生素耐药感染而生病,至少有23,000人因此死亡。如果算上欧洲,抗生素耐药感染将使年死亡人数增加到至少5万人。再加上世界其他地区,这个数字将达到数十万。
“我们没有想到细菌能够如此迅速地改变和适应。基本上,细菌的进化是以20分钟为时间尺度进行的。人类大约需要20年才能繁衍后代,而细菌每20分钟就分裂一次,测试新的突变以获得选择优势。”
— Bonnie Bassler,普林斯顿大学分子生物学系主任,2009年
对细菌而言,耐药并非徒劳
那么细菌是如何对青霉素产生耐药性的呢?真正的问题是:它们怎么可能不产生耐药性呢?
仅从寿命来看,细菌是极其成功的。它们在地球生命诞生之初就已存在,那大约是35亿年前。我们生活在它们的星球上,从进化的角度来看,它们比我们更擅长在其中生存。
换句话说,使用抗生素的行为本身就不可避免地导致了药物的失败。每次暴露于药物时,细菌都有机会建立防御机制。并且,如果暴露足够频繁,它们几乎总是会这样做。
耐药链
只需少数顽强的细菌在动物体内幸存下来,耐药性就会迅速蔓延。这些耐药细菌可以传播并影响人类的食物供应。
那么现在怎么办?嗯,还有B计划、C计划和D计划……
2015年1月,由波士顿东北大学的Kim Lewis领导的一个国际科学家团队发表了一项关于发现一种新抗生素的研究。这种名为teixobactin的抗生素在杀死病原体的同时,没有表现出促进耐药性的迹象。
尽管距离人体试验还有数年时间,teixobactin在小鼠实验中已显示出巨大潜力,能消灭高度耐药的葡萄球菌菌株。但这甚至不是最令人兴奋的部分。最令人兴奋的是:研究人员通过筛选一克普通泥土发现了teixobactin。然后,他们使用一种革命性的新工艺培养了产生它的细菌,即Eleftheria terrae。
记住很重要的一点是,在所有悲观的论调中,都有聪明人在努力寻找解决抗生素耐药性的智能方案。这里还有一些其他的
噬菌体疗法
这是什么:噬菌体,或称“细菌吞噬体”,于20世纪初被发现,是一类特殊的病毒,其名称的含义已从拉丁语翻译成英语:“细菌吞噬者”。
工作原理:医生选择一种或多种病毒来治疗患者特定的细菌感染。患者通常以药丸或粉末的形式服用噬菌体,或将其作为药膏涂抹。如果病毒选择得当,它们就会去感染和杀死致病细菌,而不会伤害其他细胞。
缺点:噬菌体疗法主要在前苏联集团国家(俄罗斯、格鲁吉亚和波兰)得到了完善,这些国家的西方抗生素在铁幕落下之前一直稀缺。在美国,FDA法规禁止大多数噬菌体疗法,除非它们已经通过了临床试验的批准程序,因此许多治疗方法无法获得。不过,这种情况正在改变。2014年,美国国家过敏症和传染病研究所支持了噬菌体疗法,麻省理工学院的研究人员正在开发一种经过工程改造的噬菌体,以专门向抗生素耐药细菌递送杀伤性DNA。
增强抗生素
这是什么:细菌几乎总是会在足够长的暴露时间后对青霉素产生耐药性。而且,由于目前使用的大多数抗生素都是先前药物的增强版本,因此加强现有药物可能是应对耐药性的最快途径。
工作原理:从开始研发一种药物到将其推向市场,存在相当长的滞后期。因此,第一步是通过限制暴露来使现有抗生素更长时间地保持有效。尽管进行了广泛的教育宣传,CDC估计抗生素仍有约一半的时间未被正确处方——用于错误的疾病、不正确的剂量或无效的疗程。第二步是更加重视和提供额外激励,以寻找增强现有抗生素的方法。
缺点:时间和金钱。时间是可以节省的——通过减少不必要的处方和几乎完全取消在农业中的抗生素使用。金钱是可以分配的——即使是基于现有版本的新药,将其推向市场也需要数亿美元。由于多种原因,制药公司很少愿意为抗生素进行此类投资,这很可能将资金缺口留给了其他组织,如政府机构和大学。
群体感应抑制
这是什么:这可能会让你大吃一惊:细菌之间——非常多地——进行交流。它们生活在由它们自己用一种称为生物膜的物质建造的紧密社区中。通过持续发出信号分子,它们可以与邻居就诸如是否需要繁殖到足以引起宿主感染等重要问题进行沟通。更令人惊讶的是,只有当它们知道有足够多的同类细菌来完成手头的任务时,它们才能做到所有这些。
工作原理:群体感应抑制剂会干扰或转移细菌用来感知何时达到群体数量的信号分子。如果细菌无法判断周围是否有足够多的同类来引起大规模骚乱,它们就会在孤立的无知中漂浮,直到宿主将其清除。发生这种情况时,它们就无法引起需要抗生素的感染,更不用说抗生素耐药感染了。
缺点:尽管进行了超过15年的相当广泛的研究,但微生物学家仍未能找到在动物模型中,更不用说在人类模型中,能够持续可靠地工作的抗群体感应化合物。理论仍然是扎实的,但可行的疗法还需要数年时间。
从农场到餐桌
2011年,美国人使用了770万磅抗生素。同年,美国农场动物使用了近四倍的量:2990万磅。
这会产生真实的影响。两年前,《消费者报告》测试了从全国各地商店购买的鸡胸肉,发现约有一半被三种或三种以上人类常用抗生素耐药的细菌菌株污染。去年年底,中国研究人员在中国猪的养殖场发现了一种对多粘菌素(人类其他抗生素失效时的最后一道防线)高度耐药的大肠杆菌菌株。
万岁,抵抗!
这18种细菌构成了一个微生物的“恶人画廊”,它们对现有最好的抗生素表现出不同程度的耐药性。CDC将每一种按威胁级别分类:紧急、严重或令人担忧。
紧急
艰难梭菌
在美国,近50万人因艰难梭菌过度生长而患上慢性腹泻。每年约有15,000人因此死亡。
碳青霉烯类耐药肠杆菌科
“CRE是噩梦细菌,”CDC主任Tom Frieden警告说。“我们最强的抗生素不起作用。”在医院中发生CRE感染,致死率接近50%。臭名昭著的大肠杆菌属于这一类。
淋病奈瑟菌
在中世纪被称为“燃烧的危险病”的同一种淋病奈瑟菌,每年感染82万美国人。其中三分之一会感染耐药性淋病,这种情况可能很快就无法治愈。
严重
多重耐药不动杆菌
这是一种机会性感染,侵袭那些已经因另一种疾病而病危的人,约影响12,000名美国人。至少有三种不同类别的抗生素对不动杆菌不再有效。
耐药弯曲杆菌
美国每年至少有130万例弯曲杆菌感染,通常由食用受污染的食物引起。四分之一的病例对青霉素耐药。
耐氟康唑念珠菌
虽然不是细菌,但这种真菌念珠菌正以比药物氟康唑更快的速度繁殖,其过度生长会导致细菌性血液感染和败血症。
广谱β-内酰胺酶肠杆菌科 这是一个广泛的微生物类别,可引起尿路感染和肺炎。它正在迅速对最强的抗生素产生免疫。
耐万古霉素肠球菌
肠球菌在医院中繁衍,引起手术感染或其他并发症。约有三分之一的感染对首选抗生素万古霉素产生耐药性。
多重耐药铜绿假单胞菌
另一种常见于医院获得性感染的细菌。在每年51,000例感染中,有6,700例对多种抗生素耐药。
耐药性非伤寒性沙门氏菌
这些细菌是导致最严重食物中毒的原因:每年有120万例严重的胃肠道疾病。其中十分之一的病例对青霉素耐药。
耐药性志贺氏菌
在美国,每年有50万例感染,其中27,000例对青霉素耐药,其慢性后果可能是一种可能终生的关节炎。
耐甲氧西林金黄色葡萄球菌
MRSA是“超级细菌”中最丑陋的一种,可引起从致命性肺炎到毁容性皮肤感染的各种疾病。它每年杀死超过11,000名美国人,约占感染者的七分之一。
耐药性肺炎链球菌
肺炎链球菌是该国细菌性肺炎和脑膜炎的第一大病因。它还会引起耳朵和鼻窦等较轻的感染。在每年120万例感染中,有7,000例是致命的。
耐药性肺结核 肺结核起源于7万多年前,被称为历史上最大的杀手。在20世纪初,美国和欧洲每7人中就有1人死于当时被称为“痨病”的疾病,而其他人则终生被隔离在疗养院。1943年第一种有效抗击肺结核的抗生素链霉素的发现,以及后来的抗生素,几乎消灭了这种疾病。但现在它又在卷土重来。在美国每年10,500例病例中,有1000多例对青霉素反应不佳——甚至完全无效。
令人担忧
耐万古霉素金黄色葡萄球菌
金黄色葡萄球菌寄生在皮肤上,通常无害。但它可以通过医疗程序(如导管插入)进入体内并引起全身感染。这种情况很少发生,也没有现成的治疗方案。
耐红霉素A组链球菌
这是一种形形色色的疾病——包括链球菌性咽喉炎、猩红热、风湿热、中毒性休克综合征和食肉病。每年约有1,300例此类感染对药物产生耐药性,其中160例是致命的。
耐克林达霉素B组链球菌
B组链球菌感染每年至少使27,000名美国人患病,其中7,600人对青霉素反应不佳。约有440人会因此死亡。